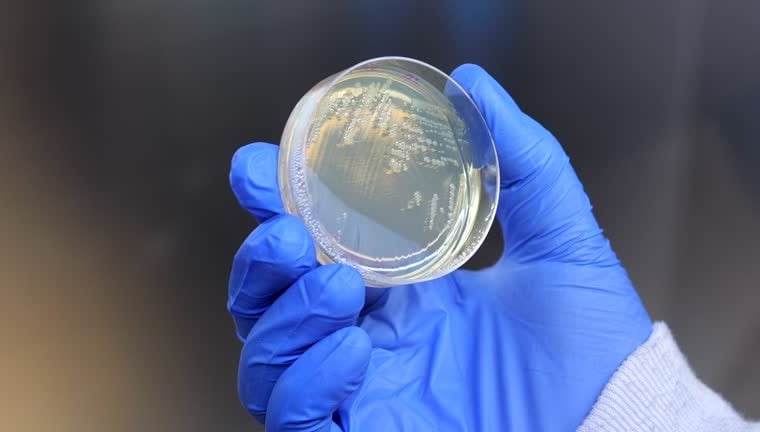

Premium Agar from Sustainable Red Algae
Leading supplier of high-quality phycocolloid products worldwide since 2008.
Premium Agar Powder: The Natural Essence from Hainan's Bays
Discover our premium agar powder extracted from natural red algae growing in the pristine bays of Hainan, China. With its unique geographic advantages, unpolluted waters, and abundant sunlight, Hainan provides the perfect environment for the growth of high-quality red algae.








Hainan’s Geographic Advantage:
Located on the shores of the South China Sea, Hainan Island is renowned for its crystal-clear waters, warm climate, and unspoiled ecosystems, making it an ideal location for natural red algae cultivation.
Superior Hainan Red Algae:
We select premium red algae (Gracilaria officinalis) harvested from natural bays, rich in nutrients, to produce agar with exceptional strength, transparency, and vibrant appearance.
Natural Growth Environment:
Leveraging Hainan’s pristine conditions, our red algae thrive in clean, pollution-free waters, far from industrial activity, ensuring unparalleled quality.


Our Factory Excellence:
Our state-of-the-art facility in Laocheng Economic Development Zone, Chengmai County, spans 36 acres and features cutting-edge production equipment and stringent quality management systems, meeting global standards.
High-Quality Agar Product:
Known for its superior gel strength 1200g/cm2, exceptional clarity, and fine appearance, our agar is trusted worldwide for applications in food, scientific research, cosmetics, and more.


Purely Plant-Based for a Sustainable Future
We are committed to producing 100% natural, plant-based agar that aligns perfectly with vegan principles, making it an ideal choice for a sustainable and health-conscious lifestyle.
Customized Agar Products
We understand that every industry has unique requirements. That's why we offer tailored agar solutions to match your exact specifications. Our team of experts works closely with you to create products that deliver the results you need.


Customizable Features:
Gel Strength: Adjusted to meet specific gelling requirements.
Particle Size: Finely tuned for your production processes.
Transparency: Enhanced clarity to suit specialized applications.
Packaging: Flexible options, including small packs (e.g. 1kg, 5kg) and bulk bags (e.g. 25kg).
And more...


Global Shipping
From our state-of-the-art production facility in Hainan, China, we deliver our high-quality agar products to clients across the globe. Whether you're in Europe, Asia, the Americas, or beyond, our reliable logistics network ensures timely and secure deliveries.


150+
Global Reach
Trusted by businesses in Spain, Germany, Italy, the Netherlands, Japan, South Korea, Thailand, and more.
Partnerships with leading shipping providers to offer fast and secure transportation.
20+
Logistics Partner




Fully compliant with export regulations and safety certifications, including CQC, HACCP, ISO, and FSSC.
International Standards
Quality Phycocolloid Products
Delivering superior agar solutions for food, pharmaceuticals, and cosmetics industries worldwide since 2008.
Sustainable Agar Solutions
Our agar is derived from natural red algae, ensuring high strength and exceptional quality for all applications.

Innovative Product Development
Focused on innovation and sustainability, we continuously improve our products to meet industry standards.


Customer Reviews
See what our customers say about our premium agar products.
Longway's agar has transformed our products with its exceptional quality and strength.
Alejandro García Sánchez
Spain
The transparency and appearance of Longway's agar are unmatched in the industry.
Lukas Müller
German
★★★★★
★★★★★
Quality Guarantee
Contact us
Leave your interests!
© 2024. All rights reserved.
From Hainan to the World:
We shipping globally. Choose our agar and let the power of nature elevate your industry!
A Leading Supplier of Premium Agar Derived from Natural Red Algae in Hainan’s Bays
